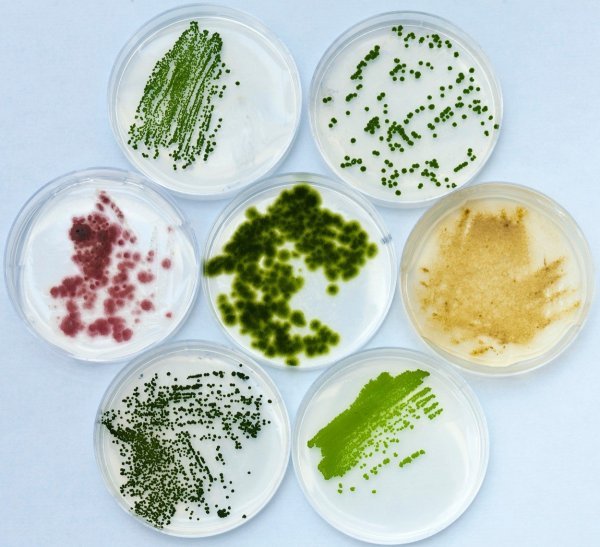
Alge

Stara izreka kaže da je najbolja sezonska hrana, uzgojena u vlastitom vrtu. No kako je sve manje ljudi u svijetu u prilici jesti ono što je ubrano ili uzgojeno u vlastitom podneblju, jedu se i mnoge vrste namirnica uvezene iz dalekih zemalja ili uzgojene u laboratorijskim uvjetima
Chia, asai, goji, Nigella sativa, noni, krill, hidiki, kelp... Tržište je preplavljeno hranom i dodacima prehrani za koje još nedavno nismo ni znali da postoje ili smo eventualno čitali o njima. Oni skloniji istraživanju novih okusa već su naučili da meso krokodila vuče malo na ribu, malo na prase, da je zebra okusom nalik konjetini ili da je Australcima klokan kao Istranima boškarin. U medijima su se mogli pronaći i recepti za burgere od krokodila te gulaš od zebre ili klokana s gljivama.
Jelovnici se mijenjaju, a s njima i naše prehrambene navike. A da u sebe ne unosimo baš sve što nam padne na pamet, brine se Europska komisija koja je osmislila i ozakonila termin nove hrane. Na njihovim internetskim stranicama nalazi se i cjelovit katalog autoriziranih novel foods, baš kao i popis odbijenih prijedloga.
Sušeni brašnar, prženi zrikavci i ekstrakt pijetlove kreste
Na najnovijem popisu zahtjeva za legalizaciju i puštanje u promet ističu se sušeni manji brašnar i njegova larva, skakavci, prženi kućni zrikavci, ekstrakt kore magnolije za izradu žvakaćih guma, ulje izvučeno iz lignji, proteini iz svinjskih bubrega, pa i ekstrakt pijetlove kreste. U ovom slučaju riječ je o zeljastoj biljci, a ne gospodaru kokošinjca, da ne bude zabune.
Što je dakle nova hrana, pitamo i dr.sc. Leu Pollak, voditeljicu Odjela za dodatke prehrani i biološki aktivne tvari pri Hrvatskom zavodu za javno zdravstvo, čija je Služba za zdravstvenu ekologiju procjenjuje.
'Termin obuhvaća svu hranu koja se nije u značajnoj mjeri upotrebljavala za prehranu stanovnika EU-a prije 15. svibnja 1997.', objašnjava dr. Pollak. 'Odnosi se na nove izvore hrane ili novoproizvedenu i inovativnu hranu, onu proizvedenu upotrebom novih tehnologija i proizvodnih postupaka te hranu koja se tradicionalno konzumira izvan, ali ne i unutar EU-a.'
'Nova hrana regulirana je uredbom EU-a, no to ne znači da će na deklaraciji hrane ili dodataka prehrani biti napisano o čemu je riječ. Taj podatak bit će poznat proizvođačima, kontrolnim kućama i nadležnim ministarstvima', pojašnjava dr. Pollak.
Mikroorganizmi, gljivice i alge
Složena stručna terminologija traži pojašnjenje koje smo potražili od prof.dr.sc. Suzane Rimac Brnčić s Prehrambeno-biotehnološkog fakulteta u Zagrebu, a koja drži predmete Nova hrana i Procesi pripreme hrane.
'Kad se govori o hrani izoliranoj iz životinja, misli se na životinjske ekstrakte i pripravke u kojima je spoj selektivno koncentriran. Takvi izolati obično se dalje rafiniraju da se dobije više ili manje čist spoj koji se ugrađuje u druge namirnice, poput goveđeg laktoferina i ulja antarktičkog krila', objašnjava Rimac Brnčić.
Pod novu hranu mogli bi uskoro spadati i - kukci. Podneseno je nekoliko zahtjeva vezanih uz cjelovite kukce ili u obliku praha, ali zasad još nije odobren nijedan zahtjev. Odobrenje nije dobilo ni laboratorijski uzgojeno meso, ali zato jest neka hrana koja se sastoji ili je proizvedena od bilja, mikroorganizama, gljivica i algi ili je pak izolirana iz njih. Na primjer, ulje mikroalge Schizochytrium sp. bogato DHA-om ili arahidonskom kiselinom bogato ulje iz gljive Mortierella alpina.
'Postupak odobrenja mora proći i hrana kojoj su sastav ili struktura toliko promijenjeni da to utječe na njenu nutritivnu vrijednost, metabolizam ili razinu nepoželjnih tvari. Upravo stoga u novu hranu spada i kravlje, punomasno i djelomično obrano mlijeko, obrađeno UV zračenjem nakon pasterizacije. Naime, UV zračenjem povećava se koncentracija kolekalciferola, vitamina D3. Takvo mlijeko nema nutritivnih nedostataka. Čak je i rizik od alergijskih reakcija isti kao u slučaju konvencionalnog mlijeka', kaže Rimac Brnčić.
Insekti i krokodili uskoro na jelovniku
Brojni su primjeri nove hrane koju redovito konzumiramo: noni, betaglukan iz kvasca, već spomenuto ulje krila, UV tretirani kvasac te gljive. Ipak, pravi šampion novel fooda svakako su chia sjemenke koje nalazimo doista posvuda - u rinfuzi, kruhu i pekarskim proizvodima, mliječnim proizvodima, voćnim sokovima i prerađevinama... Ubrzo se očekuje stavljanje na tržište insekata i krokodilskog mesa', najavljuje dr. Pollak.
Možemo li biti sigurni u svu tu nama dosad nepoznatu hranu?
'Važno je napomenuti da nova hrana prije stavljanja na tržište prolazi kroz brojnu proceduru na različitim razinama, od Europske komisije i Europske agencije za sigurnost hrane, preko Radne skupine za novu hranu, do nadležnih nacionalnih tijela, pa nema bojazni za zdravlje potrošača ukoliko se konzumira u preporučenoj količini', uvjerava nas dr. Pollak.